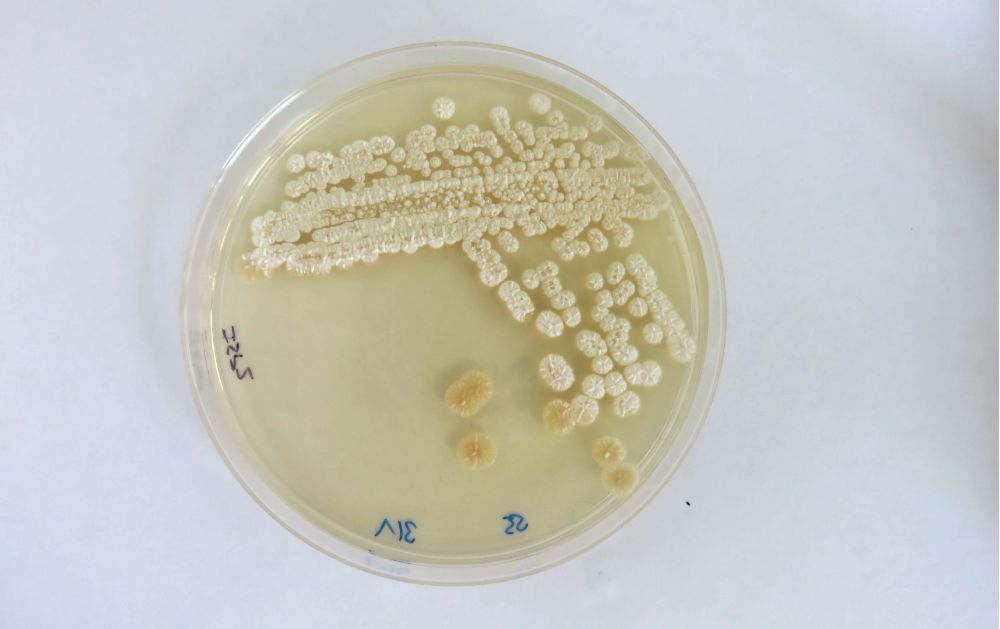
cebib
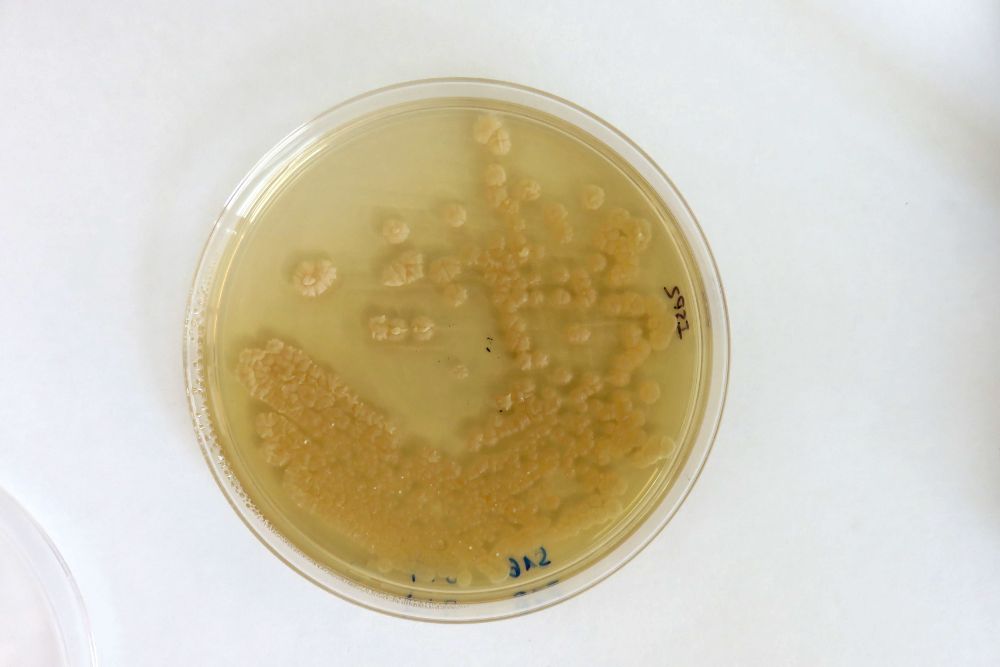
cebib

La reciente investigación liderada por Valeria Razmilic, doctora en Ciencias de la Ingeniería con especialización en Ingeniería Química y Biotecnología, abre nuevas puertas en el estudio de compuestos con potencial anticancerígeno, extraídos de microorganismos del desierto de Atacama. Este proyecto, desarrollado en el marco de un Fondecyt Postdoctorado 2021 de la Agencia Nacional de Innovación y Desarrollo, concluyó exitosamente, sentando las bases para futuras aplicaciones biotecnológicas y farmacéuticas de los lazo péptidos.
El proyecto, “Production of lasso peptides from actinobacteria isolated from the Atacama Desert as a novel source of bioactive compounds” fue liderado por la investigadora postdoctoral del Centro de Biotecnología y Bioingeniería (CeBiB) y finalizado en abril de este año.
Compuestos únicos para combatir el cáncer
Los lazo péptidos son pequeñas moléculas sintetizadas por bacterias, compuestas por aminoácidos, similares a las proteínas, pero de menor tamaño. Su estructura única forma un anillo, con una cola de aminoácidos que pasa a través del mismo, creando una forma de lazo, de donde proviene su nombre.
"Esta estructura les confiere resistencia a las temperaturas y a otras enzimas que los podrían querer cortar o eliminar. Entonces, esa es una de las gracias de esta estructuras, que son más resistentes a acciones biológicas dentro de los microorganismos y a condiciones abióticas (no biológicas)”, explicó Valeria Razmilic. Según lo señalado por a investigadora, estos péptidos son muy variados y se han encontrado en diversas bacterias mediante técnicas de bioinformática. Algunos presentan actividades antibióticas, anticancerígenas y antivirales, lo que despierta un gran interés en su estudio y potencial aplicación en la industria farmacéutica y biotecnológica.
El proyecto de Razmilic se enfocó en la identificación y producción de lazo péptidos en bacterias aisladas del desierto de Atacama, un entorno conocido por su aparente hostilidad pero que alberga una rica diversidad de microorganismos. Durante su investigación, se identificaron seis bacterias productoras de estos péptidos, incluyendo tres que corresponden a nuevas variantes no descritos previamente en la literatura científica.
Los principales objetivos del trabajo fue investigar y caracterizar lazo péptidos en bacterias aisladas del desierto de Atacama, así como determinar las diversas actividades biológicas de los péptidos identificados, como antibióticas, anticancerígenas y antivirales. Además, desarrollar métodos para aumentar la producción de estos péptidos en bacterias, explorando su potencial farmacéutico y biotecnológico. Específicamente, usando modelos metabólicos para predecir formas en las cuales se puede mejorar la producción de los lazo péptidos. Finalmente, confirmar la estructura y funciones de los péptidos mediante técnicas avanzadas como la resonancia magnética nuclear y bioensayos específicos y aportar nuevos conocimientos sobre la biodiversidad microbiana del desierto de Atacama y su potencial para la investigación biotecnológica y farmacéutica.
El enfoque metodológico del proyecto incluyó la clonación de genes responsables de la síntesis de lazo péptidos en cepas bacterianas diseñadas para facilitar su detección. De los seis péptidos identificados, cinco fueron clonados y se logró la detección de dos, uno nuevo y otro ya conocido. Aunque los ensayos de actividad antibiótica no fueron concluyentes, esto no descarta otras posibles bioactividades que aún están por explorarse.
Si bien el proyecto fue finalizado, Razmilic continúa trabajando en el CeBiB, enfocada en incrementar la producción de los péptidos y explorar su potencial anticancerígeno y antiviral en colaboraciones futuras. Por otra parte, investigadora mencionó la posibilidad de colaborar con investigadores en Aberdeen para confirmar las estructuras de los nuevos péptidos mediante resonancia magnética nuclear. Además, no descarta enviar muestras a laboratorios especializados para evaluar su actividad biológica.
El trabajo de la doctora Valeria Razmilic destaca la importancia de la investigación en biotecnología y el potencial de los microorganismos del desierto de Atacama. Asimismo, la investigadora destaca instalaciones adecuadas y el entorno propicio para la investigación con las que cuenta el Centro Basal CeBiB para el desarrollo de nuevas soluciones biotecnológicas.